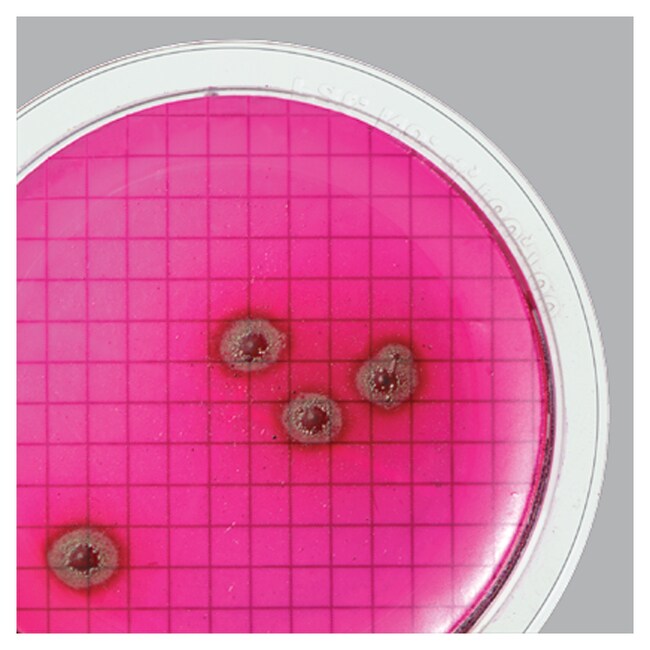
WaterBugs&trade; 铜绿假单胞菌 ATCC&trade; 27853&trade;

Search
Thermo Scientific™
WaterBugs™ 铜绿假单胞菌 ATCC™ 27853™
用于水/废水质量控制检测;以 Quanti-Cult™ 形式提供微生物。
| 货号 | 数量 |
|---|---|
| R4757060 | 10次检测/套装 |
货号 R4757060
价格(CNY)
-
数量:
10次检测/套装
Thermo Scientific™ WaterBugs™ 铜绿假单胞菌 ATCC™ 27853™ 用于水/废水质量控制检测;微生物以 Quanti-Cult 形式提供。
- 在单个接种物中递送 < 50 CFU 以模拟水样
- 1 次检测/复溶瓶
订货提示:
提供 10 个微生物保存样品瓶,10 个再水合样品瓶
*ATCC Licensed Derivative Emblem、ATCC Licensed Derivative 文字商标和 ATCC 目录商标均为 ATCC™ 的商标,并根据授权使用。
规格
ATCC®27853TM*, 27853™*
描述铜绿假单胞菌 ATCC™ 27853™
产品规格Quanti-Cult
包装类型10次检测/套装
数量10次检测/套装
应变指示Boston 41501
产品类型质控微生物
靶标有机物类革兰氏阴性杆菌
测试类型定量 QC
Unit SizeEach